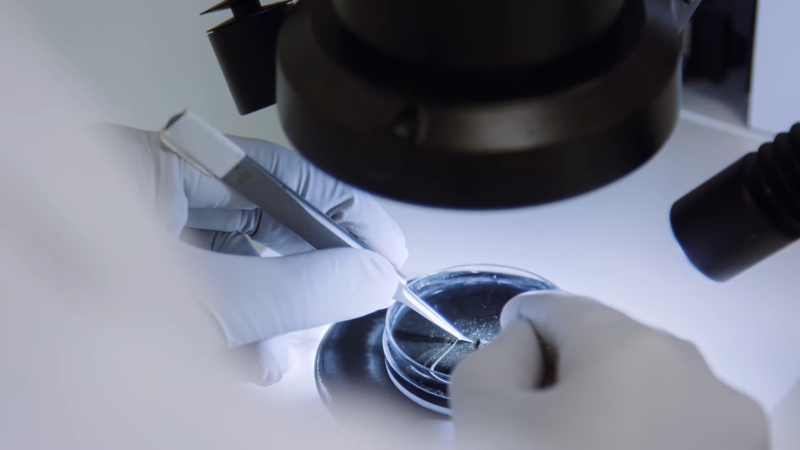
call for proposals for clinical research

DISCOVER OUR FONDATION
Fondation Pour l’Audition was created by Françoise Bettencourt Meyers, Jean-Pierre Meyers and the Bettencourt Schueller Foundation. It has been recognized as a public-interest organization since 2015. Its mission is three-fold: supporting research and innovation to offer new hope; informing the public to protect hearing health through prevention and awareness initiatives; and improving the lives of people with hearing disorders.


OUR RESEARCH MISSION
"Fondation Pour l'Audition creates the conditions to improve knowledge, accelerate research and innovation for all hearing disorders. Present at every stage of research, the Fondation encourages the development of research excellence, solutions and medical innovations to answer the daily needs of those affected"
Dr. Marie-Josée Duran, PhD, Chief Scientific Officer
Apply to our support program for scientific and medical research
Fondation Pour l’Audition aims to accelerate breakthroughs in hearing health by encouraging research and scientific innovation.
16 million people in France are affected by some form of deafness, hearing loss or tinnitus. Hearing aids and cochlear implants provide invaluable support but there is currently no cure and there is some way to go before we can fully understand these disorders and offer much-needed solutions.
Accelerating scientific and medical research in hearing
With our supports program, Fondation Pour l’Audition aims to accelerate breakthroughs in hearing health by encouraging research and scientific and medical innovation:
- By supporting French research laboratories in the field of hearing health through calls for proposals, scientific prizes and open requests.
- By sponsoring the creation of the Institut de l'Audition, in Paris, the first multidisciplinary hearing science research center, bringing together the world’s best scientific and medical teams to advance research and develop new solutions.
- By supporting the creation of Audiology Research Centres, clinical research platforms in audiology, which will facilitate the development of therapeutic and diagnostic solutions.
Since 2024, Institut de l'Audition and Audiology Research Centres are part of the reConnect Institute, a University Medical Institute recognized by the French state, created by Fondation Pour l'Audition, Institut Pasteur, the Paris hospital system (AP-HP), Inserm and Paris-Cité University.
NEW: Apply to the call for proposals for clinical research
By stimulating new approaches and supporting excellent pioneering research, FPA wishes to promote innovative therapeutic clinical studies that will improve our hearing health in the future and contribute to France’s influence in Hearing Sciences.
CURRENTLY CLOSED.

Apply to the call for proposals for laboratories
With this call, Fondation Pour l'Audition support hearing research excellence in French laboratories. Collaboration with foreign teams are encouraged.
CURRENTLY CLOSED.
Our scientific prizes
Fondation Pour l’Audition is reinforcing its commitment by encouraging talents and paying tribute to scientific breakthroughs in France and worldwide, with 2 prizes delivered every year.
CURRENTLY CLOSED.


Hearing innovation chairs
The call for FPA Hearing Innovation Chairs will enable the launch of innovative projects in the field of hearing
CURRENTLY CLOSED
Our scientific and medical research laureates
Fondation Pour l'Audition has awarded many laureates in all areas of hearing research.
Promoting research in Human and Social Sciences
Fondation Pour l'Audition is developing social programmes to support people with hearing disorders at key stages in their lives (Education, Youth, Work, Ageing), and raises awareness to prevent hearing disorders.
To structure and plan these actions, the Foundation needs clear and precise scientific data to understand the daily problems faced by those affected and assess the associated public policies.
The Foundation launches a program to support research in Human and Social Sciences to improve our knowledge on these issues and come up with solutions to better support the people affected in their day-to-day lives.
A Human and Social Sciences research committee has been created to meet this ambition.

Call for Human and Social Sciences projects
The challenges to improve the daily lives of people affected by hearing disorders are numerous and require a global approach.
To tackle these challenges, Fondation Pour l'Audition and International Foundation of Applied Disability Research (FIRAH) launch a call for applied research projects, the general aim of which is to produce knowledge that will improve the lives of people affected by hearing disorders.
Projects must be carried out by a joint participatory research team comprising researchers and players of the field, i.e. people affected, their families and closed ones, their representative organisations and other players of the society such as associations, private organisations, public sector, etc.
CLOSING MARCH 23, 2026

